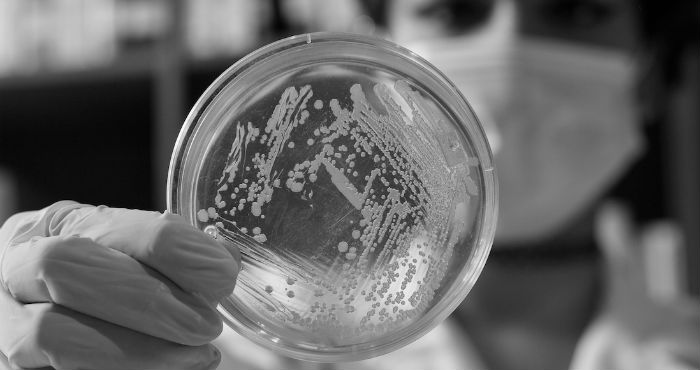
Cultivo de E.colli. Foto: MFernanda Contreras.

Leslie García y Paloma López son un colectivo mexicano que conjunta el arte, la ciencia y la tecnología para crear experimentos audiovisuales. Vice platicó con ellas sobre su proyecto Energy Bending Lab.
Por Luis Carreño, The Creators Project
La experimentación ha sido un proceso clave en la producción y consolidación musical. Ritmos y melodías populares han surgido gracias a la exploración libre que artistas han realizado, dándole imagen y personalidad a nuevas tendencias sonoras que han dejado atrás su carácter experimental para convertirse en pautas claras de producción.
Platicamos con Interspecifics, un colectivo mexicano formado por Leslie Garcia y Paloma López, dos artistas que crean experiencias audiovisuales a partir de microorganismos. A través de la actividad bioeléctrica de estas formaciones, Interspecifics explora la intersección del arte y la tecnología, demostrando ante su audiencia de manera creativa los procesos de micro-comunicación existente.
– ¿Cuál es su primer acercamiento artístico con las bacterias? ¿Cómo surge su interés?
– Nuestro acercamiento es sobre todo filosófico, comenzamos trabajando con bacterias porque son organismos altamente especializados que han evolucionado por millones de años en el mismo planeta donde nosotros habitamos. El nivel celular para nosotros representa una de las dimensiones más diminutas de la realidad con la que nos es posible interactuar. La primera bacteria con la que trabajamos fue la famosa E.colli y después de un tiempo nos fascinaron las geobacters y su capacidad de producir energía bioeléctrica.
Una de la ideas que más nos intrigan es la capacidad sensorial de estos organismos, cómo perciben ellos su entorno y cómo ese percepción afecta nuestra construcción colectiva de la realidad. Partiendo de esta idea cada organismo percibe desde la capacidad de su interface sensorial y eso es lo que constituye lo que afirmamos como realidad. Para poder trabajar esta teoría desarrollamos un dispositivo llamado Energy Bending Lab un instrumento compuesto por un conjunto de sintetizadores modulares hechos a medida y herramientas de transducción que crean una sonificación en tiempo real de las propiedades eléctricas se encuentran en algunas bacterias.
– ¿Creen que la ciencia, el arte y la tecnología están estrechamente relacionados?
– Sí lo creemos, pero no solamente arte y tecnología, también el diseño y la ingeniería. Se trata de la relación que guardan las principales áreas de expresión de la creatividad humana y las preguntas fundamentales que las impulsan y alimentan.
Recientemente Neri Oxman publicó en el Journal of Design and Science del MIT un artículo llamado “The Age of Entanglement” donde describe dichas relaciones. El rol de la ciencia, dice, es explicar y predecir el mundo que nos rodea, convirtiendo información en conocimiento. El rol de la ingeniería es aplicar el conocimiento científico para el desarrollo de soluciones a problemas empíricos, convirtiendo el conocimiento en utilidad. El diseño por su parte aumenta la capacidad utilitaria de la ingeniería produciendo comportamiento en torno a soluciones. Y el arte se encarga precisamente de cuestionar ese comportamiento y crear conciencia del mundo que estamos construyendo, convirtiendo el comportamiento en percepción.

– ¿Qué desafíos se presentaron con la creación del Energy Bending Lab? ¿Cómo consiguieron llegar al resultado que buscaban?
– En nuestro caso casi siempre el primer desafío está en la investigación que hay que emprender del tema que queremos tratar. Nosotras no somos expertas en ninguna de las áreas que estudiamos e incluso en numerosas ocasiones se puede decir que el proyecto a desarrollar es nuestra primer aproximación al tema. Pero precisamente nos interesa mantener una mente de principiante ya que es en este fase donde el mundo se presenta con más opciones y posibilidades.
En el caso del Energy Bending Lab, tuvimos que estudiar primero sobre el comportamiento de bacterias, su biología, proceso de comunicación, desarrollo, etc. Nuestro primer encuentro con la microbiología en general. Por otro lado si bien teníamos algo de experiencia con la electrónica, también fue la primer vez que trabajamos sobre el formato de Euroracks y tuvimos que aprender de cero las características y especificaciones de cómo se trabaja este formato que se popularizó tanto gracias a los modelos de la famosa empresa alemana Doepfer.
Para nosotros el desarrollo de los proyectos que emprendemos significa una posibilidad de generar conocimiento y de compartirlo, en este caso los desafíos son realmente la posibilidad de abordar ese conocimiento desde campos muy diversos, y continuar con una forma ordenada y clara de divulgación.
En la tradición de la inventiva mexicana fue difícil encontrar instituciones que pudieran apoyar el desarrollo de nuestra investigación. Al parecer en México la investigación artística dentro de instituciones formales está enfocada más en la creación de acervo y archivo, y no tanto a la producción y al uso del arte como estrategia y metodología de desarrollo. Aquí aún no queda claro si uno es artista, ingeniero o investigador, cosa que realmente no importa.
Al final de cuentas conseguimos los fondos y el soporte necesario para nuestra investigación, lo cual nos obligó a trabajar durante dos años fuera de México, sumergidas en una rutina de nómadas, transitando entre fablabs, makerspaces y cualquier laboratorio abierto similar. El proyecto fue fondeado por dos organizaciones, por un lado la red ECAS (European Cities of Advanced Sound) durante el 2014, como parte de una residencia que se desarrolló entre las ciudades de Bruselas, La Haya y Tromso en Noruega. En 2015 nos integramos al proyecto Phychip en la Universidad Bauhaus en Alemania como investigadoras artísticas, donde tuvimos la posibilidad de continuar con el proyecto expandiendo sus posibilidades como herramienta de sonificación no solo con bacterias sino también con organismos como el Physarum Polycephalum. Para nosotros fue muy importante contar con el respaldo de estas organizaciones, sin embargo esta experiencia lo único que fomentó en nosotros fue la necesidad de reactivar este tipo de espacios en México y nuestra siguiente fase es la producción de una serie de interfaces como el EBL que sean imaginados, diseñados y producidos localmente.
– ¿Los visuales generados tienen un fuerte relación con el sonido?
– En el caso del EBL los visuales son una mezcla compleja entre imágenes de microscopios de alta y baja resolución en vivo y de archivo, y el screencast de algunos de los softwares que utilizamos para hacer análisis de patrones. Son parte del acto en vivo como forma de convertir el espacio en un laboratorio donde se realiza un experimento en tiempo real del cual todos somos partícipes; donde los organismos con los que trabajamos están siendo influenciado por nosotros, pero al mismo tiempo nosotros somos influenciados por ellos. Se trata de un loop de influencia derivado de ideas de la cibernética de segundo orden, nosotros no buscamos un control absoluto de nuestro instrumento sino que preferimos buscar patrones de auto-organización que emerjan a través del sonido y la imagen.
– ¿Cuál es el proceso por el que tienen que pasar la muestras bacteriana antes de convertirse en sonido?
– Hemos trabajado con distintos procesos y todos tienen resultados diferentes. En alguna ocasión trabajamos con cepas aisladas de e.colli, un solo tipo de bacteria en una comunidad controlada, el resultado del sonido era demasiado lineal y predecible. Entonces decidimos trabajar con consorcios de bacterias para utilizar otros comportamientos más complejos que ocurren en comunidades. Para esto diseñamos distinta celdas de combustible microbiano, donde eliminamos el flujo de oxígeno para despertar un proceso que sustituye a la respiración a partir de intercambiar electrones, literalmente cosechar la energía de estas bacterias. En el caso del Physarum es necesario usar un sistema diferente y todo el proceso comienza despertando al micro-organismo a partir de humedad y monitorear su crecimiento en un electrodo especial que diseñamos. Cada organismos tiene su propio comportamiento y esa información es la que precisamente mapeamos en características de síntesis .

– ¿Qué están explorando a través de esta transformación artística?
– Hay varios aspectos que estamos explorando, por un lado se encuentra la producción y el transmisión descentralizada del conocimiento, por décadas los nichos del conocimiento han sido las universidades y las corporaciones, ellas son las que resguardan quiénes y cómo pueden acceder al conocimiento. Para nosotros este tipo de proyectos nos permite plantear un hecho fundamental, el conocimiento es un bien común al alcance de quien lo busca. Por eso que es tan importante para nosotros mantener la información de nuestros proyectos abiertos desde el principio, como una forma de crear redes y comunidad. Y creemos orgullosamente que lo estamos comenzando a lograr, tenemos una red de colaboradores muy cercanos en varias partes del mundo.
Por otro lado nuestros intereses más ontológicos tienen que ver con explorar la capacidad que cada organismo vivo tiene para comprender y relacionarse con su espacio y cómo esa compresión es resultado de sus capacidades sensoriales, a lo que nosotros nos referimos como Interface sensorial. Creemos que como seres humanos las limitaciones de nuestra interface juegan un gran papel en todas nuestras decisiones y en la forma en la que estamos afectando nuestro entorno. En nuestro caso las condiciones son muy específicas, nuestro sentido de la escucha está limitado por un rango entre 20 Hz y 20KHz nuestro sentido de la visión sólo es capaz de recibir el rango medio de energía del espectro electromagnéticos etc. Y nosotros nos preguntamos ¿qué pasaría si fuéramos capaces de percibir a través del otro? ¿Podríamos extendernos sensorialmente? Crear agenciamientos interespecie y de esta forma aumentar la conciencia de lo que percibimos como realidad. En otras palabras exploramos el efecto de los sentidos en términos de la realidad que construimos. Y creemos que es posible afectar esa construcción.
– ¿Existe alguna relación entre el universo y el humano a través de la vibración?
Hay una línea de investigación abierta dentro de la física que se conoce como Unified Field Theory donde se busca posicionar todas las fuerzas y las partículas elementales dentro de un solo campo. También otra teoría que sigue abierta y que no ha podido ser comprobada es el String Theory, que habla de la vibración y la resonancia como los campos fundamentales que mantienen este universo. En ambos casos la ciencia está tratando de explicar la relación que guardan todas las fuerzas del universo con los elementos más simples como nosotros, y donde la vibración tiene un papel fundamental como el lenguaje de programación que construye el universo y sus habitantes como los conocemos.
Por otro lado las diferentes formas de energía que conocemos de nuestro planeta poseen características de onda: frecuencia, fase, amplitud, etc. En ese sentido hay una oscilación inherente que está presente en varias dimensiones que atraviesan desde lo cuántico hasta lo macróscopico, pasando obviamente por lo celular.
Mira las bitácoras de trabajo de Interspecifics aquí.
ESTE CONTENIDO ES PUBLICADO POR SINEMBARGO CON AUTORIZACIÓN EXPRESA DE ViceMedia. Ver ORIGINAL aquí. Prohibida su reproducción.



















































